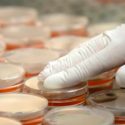

Un estudio publicado en la revista “mBio” dio a conocer que el cambio climático es responsable de la superbacteria Candida auris la cual resistente a los fármacos; esta fue descubierta en 2009 y 10 años después apareció en 30 países de todo el mundo.
El doctor Arturo Casadevall, presidente de microbiología molecular e inmunología de la Escuela de Salud Pública Bloomberg de Johns Hopkins, y colaborador del estudio consideró que el calentamiento global “puede conducir a nuevas enfermedades fúngicas que ni siquiera conocemos en este momento”.
Para el estudio, los investigadores sometieron a altas temperaturas a la Candida auris y descubrieron que era capaz de adaptarse y crecer más que otras bacterias parecidas.
Algunos pacientes de acuerdo con los Centros para el Control y la Prevención de Enfermedades de Estados Unidos, pueden sufrir de infecciones en la sangre por esta bacteria, ya que representa una “seria amenaza para la salud global”.
Fuente: adn40.mx